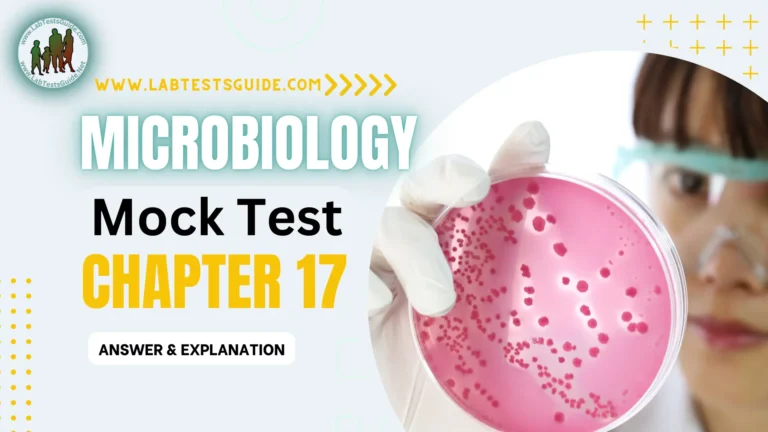

Prepare for your certification exams with Chapter 41 of our Mock Test for Lab Technicians and Technologists. This thorough evaluation covers crucial areas such as anatomy, physiology, microbiology, chemistry, and hematology, ensuring mastery in key clinical laboratory sciences. Perfect for self-assessment and exam preparation, this chapter is designed to boost your confidence and refine your test-taking abilities.

2001 to 2050 MCQs Mock Test for Lab Technician and Technologist Exam Preparation
If You like then share this to your friends and other social media.
If You have any question and suggestions then please Contact us Here
Chapter 41’s questions are meticulously crafted to assess essential technical skills and knowledge in the laboratory profession. This includes interpreting laboratory test results, performing procedures accurately, and maintaining equipment effectively.
To excel in these multiple-choice questions (MCQs), candidates need a profound understanding of laboratory science concepts and principles. Mastery in using common laboratory equipment and adherence to safety protocols are crucial.
Effective preparation involves studying specialized laboratory science textbooks and engaging in relevant online courses. Practicing with sample questions and reviewing answers will help candidates identify areas for further study or improvement.
Overall, the Laboratory Technologist MCQs are designed to be both comprehensive and challenging, evaluating candidates’ advanced proficiency in laboratory sciences.